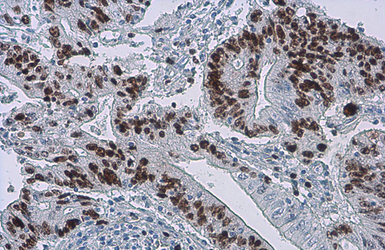
产品细节图片7

相关产品推荐更多 >
万千商家帮你免费找货
0 人在求购买到急需产品
- 详细信息
- 文献和实验
- 技术资料
- 亚型:
IgG
- 形态:
Liquid
- 保存条件:
Store as concentrated solution. Centrifuge briefly prior to opening vial. Store at 4ºC. DO NOT FREEZE.
- 克隆性:
Monoclonal
- 标记物:
Unconjugated
- 适应物种:
Human, Mouse, Rat, Chicken, Pig
- 保质期:
12 months from the shipping date of the product.
- 抗原来源:
Human
- 目录编号:
GTX16667
- 级别:
Primary Antibodies
- 库存:
Available
- 供应商:
GeneTex
- 宿主:
Rabbit
- 应用范围:
WB, ICC/IF, IHC-P, IHC-Fr, FACS, IHC
- 靶点:
Ki67
- 抗体英文名:
Ki67 antibody [SP6]
- 抗体名:
Ki67 抗体 [SP6]
- 规格:
500 μl

Ki67 antibody [SP6] detects Ki67 protein at nucleus in human cervical metaplasia (left) and carcinoma (right) by immunohistochemical analysis.
Sample: Paraffin-embedded human cervix.
Ki67 antibody [SP6] (GTX16667) diluted at 1:200.

Ki67 antibody [SP6] detects Ki67 protein at nucleus by immunohistochemical analysis.
Sample: Paraffin-embedded human breast carcinoma.
Ki67 stained by Ki67 antibody [SP6] (GTX16667) diluted at 1:200.
Antigen Retrieval: Citrate buffer, pH 6.0, 15 min

Ki67 antibody [SP6] detects Ki67 protein at nucleus by immunohistochemical analysis.
Sample: Paraffin-embedded human colon cancer.
Ki67 stained by Ki67 antibody [SP6] (GTX16667) diluted at 1:200.
Antigen Retrieval: Citrate buffer, pH 6.0, 15 min

Ki67 antibody [SP6] detects Ki67 protein at nucleus by immunohistochemical analysis.
Sample: Paraffin-embedded human endometrial carcinoma.
Ki67 stained by Ki67 antibody [SP6] (GTX16667) diluted at 1:200.
Antigen Retrieval: Citrate buffer, pH 6.0, 15 min

Ki67 antibody [SP6] detects Ki67 protein at nucleus by immunohistochemical analysis.
Sample: Paraffin-embedded human ovarian cancer.
Ki67 stained by Ki67 antibody [SP6] (GTX16667) diluted at 1:200.
Antigen Retrieval: Citrate buffer, pH 6.0, 15 min

Ki67 antibody [SP6] detects Ki67 protein at nucleus by immunohistochemical analysis.
Sample: Paraffin-embedded human cervical carcinoma.
Ki67 stained by Ki67 antibody [SP6] (GTX16667) diluted at 1:200.
Antigen Retrieval: Citrate buffer, pH 6.0, 15 min
Ki67 antibody [SP6] detects Ki67 protein at nucleus by immunohistochemical analysis.
Sample: Paraffin-embedded human colon cancer.
Ki67 stained by Ki67 antibody [SP6] (GTX16667) diluted at 1:200.
Antigen Retrieval: Citrate buffer, pH 6.0, 15 min
风险提示:丁香通仅作为第三方平台,为商家信息发布提供平台空间。用户咨询产品时请注意保护个人信息及财产安全,合理判断,谨慎选购商品,商家和用户对交易行为负责。对于医疗器械类产品,请先查证核实企业经营资质和医疗器械产品注册证情况。
 文献和实验
文献和实验Lien BV et al., Exp Neurol 2019 (PMID:30653967)
Lee J et al., J Biomed Mater Res B Appl Biomater 2018 (PMID:30419151)
Wei J et al., Cancer Med 2018 (PMID:30430771)
Yuan WC et al., Nat Commun 2018 (PMID:30446657)
Kozareva DA et al., Behav Brain Res 2019 (PMID:30481511)
Nam AR et al., Cancer Res Treat 2018 (PMID:30282449)
Beaudry K et al., J Cell Physiol 2018 (PMID:30273442)
Yrlid U et al., J Leukoc Biol 2018 (PMID:30265749)
Biehs B et al., Nature 2018 (PMID:30297801)
Min A et al., Mol Cancer Ther 2018 (PMID:30232143)
Fang CC et al., Sci Rep 2018 (PMID:30217986)
Wu CC et al., Biomaterials 2018 (PMID:30243150)
Wang SW et al., Neurosci Res 2018 (PMID:30145270)
Lin JH et al., Breast Cancer Res Treat 2018 (PMID:30054830)
Gomora MJ et al., Endocr Connect 2018 (PMID:30012649)
Yuan B et al., Oncotarget 2016 (PMID:27323858)
Nguyen QH et al., Nat Commun 2018 (PMID:29795293)
Nesset CK et al., Fibrogenesis Tissue Repair 2016 (PMID:27141234)
Schlereth K et al., Elife 2018 (PMID:29749927)
Hsieh FY et al., Biomaterials 2018 (Epub)
Min A. et al., Cancer Letters 2018 (Epub)
Li B et al., Acta Pharmacol Sin 2018 (PMID:29769743)
Eckhardt BL et al., PLoS One 2018 (PMID:29768500)
Murai K et al., Nat Commun 2016 (PMID:26965827)
Cheng YC et al., Cell Physiol Biochem 2018 (PMID:29414809)
Wu X et al., Proc Natl Acad Sci U S A 2014 (PMID:25189770)
Itoh M et al., Oncotarget 2017 (PMID:29190905)
Qian L et al., Cytotechnology 2017 (PMID:29170841)
Todoric J et al., Cancer Cell 2017 (PMID:29153842)
Bi T et al., Cytotechnology 2017 (PMID:29110119)
Cheng ZF et al., Am J Physiol Gastrointest Liver Physiol 2017 (PMID:28935684)
Wang BY et al., Nanomaterials (Basel) 2017 (PMID:28892021)
Miura A et al., Biosci Biotechnol Biochem 2017 (PMID:28914172)
Han HW et al., Colloids Surf B Biointerfaces 2017 (PMID:28743088)
Chen HC et al., Sci Rep 2017 (PMID:28785010)
Nakagawa H et al., Proc Natl Acad Sci U S A 2014 (PMID:24395807)
Kijani S et al., Physiol Rep 2017 (PMID:28716818)
Murai K et al., Proc Natl Acad Sci U S A 2014 (PMID:24927526)
Chen S et al., Proc Natl Acad Sci U S A 2017 (PMID:28167773)
Tang FR et al., Physiol Behav 2017 (PMID:28341234)
Osanai K et al., Hum Cell 2017 (PMID:28382516)
Wang LT et al., Oncogene 2017 (PMID:28368406)
Nakamura Y et al., Indian J Pathol Microbiol 2017 (PMID:28195088)
Tandon M et al., PLoS One 2015 (PMID:25747583)
Wang K et al., Immunity 2014 (PMID:25526314)
Lan T et al., PLoS One 2015 (PMID:26222337)
Liu Y et al., Technol Cancer Res Treat 2016 (PMID:26009496)
Cheng YY et al., EMBO Mol Med 2016 (PMID:28011860)
Liu XY et al., Am J Cancer Res 2015 (PMID:26693056)
Aguilera-Castrejon A et al., Neurochem Res 2016 (PMID:27804011)
Shan L et al., Sci Rep 2016 (PMID:27819329)
Liu Y et al., Apoptosis 2016 (PMID:27671687)
Lin HH et al., J. Mater. Chem. B. 2016 (Epub)
Gabriela FG et al., J CANCER 2016;7(12)
Xie C et al., Onco Targets Ther 2016 (PMID:27445491)
Liou AT et al., Sci Rep. 2016 (PMID:27499235)
Liu X et al., Drug Chem Toxicol 2016 (PMID:27250112)
de Jong PR et al., Nat Commun 2016 (PMID:27187615)
Chuang HM et al., Front Pharmacol 2016 (PMID:27199755)
Nam AR et al., Mol Cancer Ther 2016 (PMID:27196758)
Gan Y et al., Cancer Biol Ther 2016 (PMID:27104982)
Cheng YC et al., J. Nutr. Biochem. 2016 (PMID:27260469)
Antonucci L et al., Proc Natl Acad Sci U S A 2015 (PMID:26512112)
Abraham S et al., Nat Commun 2015 (PMID:26129894)
Kijani S et al., PLoS One 2015 (PMID:25739088)
Taniguchi K et al., Nature 2015 (PMID:25731159)
Yueh MF et al., Proc Natl Acad Sci U S A 2014 (PMID:25404284)
Li KC et al., Mol Cancer 2014 (PMID:25027955)
Nakagawa H et al., Cancer Cell 2014 (PMID:25132496)
Chen S et al., Proc Natl Acad Sci U S A 2013 (PMID:24191041)
Corbitt N et al., Am J Pathol 2013 (PMID:23159949)
Wang CH et al., Heart Vessels 2012 (PMID:21331618)
Bao L et al., Cancer Lett 2013 (PMID:23684551)
Chen CH et al., Mol Ther 2013 (PMID:23295948)
Grivennikov SI et al., Nature 2012 (PMID:23034650)
Perone MJ et al., J Immunol 2009 (PMID:19234158)
Zhang N et al., Nat Aging 2023 (PMID:37118121)
Chen A et al., Front Mol Neurosci 2023 (PMID:37089691)
Takasago T et al., PLoS One 2023 (PMID:36996146)
Feng XF et al., Front Cell Neurosci 2023 (PMID:37051111)
Sun Y et al., Theranostics 2022 (PMID:36438492)
Giraldo E et al., Cells 2022 (PMID:36291170)
Bartolom? A et al., Diabetes 2022 (PMID:35944274)
Weber AA et al., Nat Commun 2022 (PMID:35896521)
Polat R et al., J Clin Res Pediatr Endocrinol 2022 (PMID:35770944)
Ono M et al., Discov Oncol 2023 (PMID:36689027)
Hu Q et al., EMBO J 2023 (PMID:36382717)
Zhang Y et al., iScience 2022 (PMID:36185355)
Elsukary AE et al., Neurotox Res 2022 (PMID:35976555)
Baglieri J et al., Am J Pathol 2021 (PMID:34119473)
baibai17 今天开题,导师问了个问题:ki67为什么叫ki67?当场傻住······恳请各位老师指教!谢谢。 keavin521 The Ki-67 protein was originally defined by the prototype monoclonal antibody Ki-67 (Gerdes et al., 1983),which was generated by immunizing mice
【求助】谢谢,请问ki67、PCNA、P53的英文全称是什么?
东德公民 谢谢,请问ki67、PCNA、P53的英文全称是什么?加急,谢谢 zhujoker p53 :also known as protein 53 or tumor protein 53, is a transcription factor which in humans is encoded by the TP53 gene。 p53 is important in multicellular organisms
STM:广州医科大学刘铭/谢茂彬合作发现肝细胞癌的新潜在治疗靶点 Claudin 6
组于 Science Translational Medicine 杂志(STM)在线发表题为 Targeting tumor lineage plasticity in hepatocellular carcinoma using an anti-CLDN6 antibody-drug conjugate 的研究论文。这项研究揭示了细胞紧密连接(tight junction)蛋白 Claudin 6 通过调控肝癌细胞的谱系可塑性(lineage plasticity),促进肝癌进展与耐药的机制,并初步报道
 技术资料
技术资料暂无技术资料 索取技术资料







![CD133 antibody [6H10-F1-C11]](https://img1.dxycdn.com/2023/0711/451/6106825198874858761-14.jpg!wh200)
